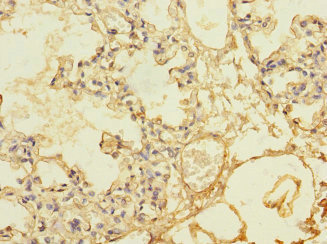

THBD Antibody
-
中文名稱:THBD兔多克隆抗體
-
貨號:CSB-PA023486DSR2HU
-
規格:¥440
-
圖片:
-
其他:
產品詳情
-
產品名稱:Rabbit anti-Homo sapiens (Human) THBD Polyclonal antibody
-
Uniprot No.:
-
基因名:
-
別名:THBD; THRM; Thrombomodulin; TM; Fetomodulin; CD antigen CD141
-
宿主:Rabbit
-
反應種屬:Human
-
免疫原:Recombinant Human Thrombomodulin protein (200-500AA)
-
免疫原種屬:Homo sapiens (Human)
-
標記方式:Non-conjugated
-
克隆類型:Polyclonal
-
抗體亞型:IgG
-
純化方式:Antigen Affinity Purified
-
濃度:It differs from different batches. Please contact us to confirm it.
-
保存緩沖液:PBS with 0.02% sodium azide, 50% glycerol, pH7.3.
-
產品提供形式:Liquid
-
應用范圍:ELISA, IHC
-
推薦稀釋比:
Application Recommended Dilution IHC 1:20-1:200 -
Protocols:
-
儲存條件:Upon receipt, store at -20°C or -80°C. Avoid repeated freeze.
-
貨期:Basically, we can dispatch the products out in 1-3 working days after receiving your orders. Delivery time maybe differs from different purchasing way or location, please kindly consult your local distributors for specific delivery time.
-
用途:For Research Use Only. Not for use in diagnostic or therapeutic procedures.
相關產品
靶點詳情
-
功能:Thrombomodulin is a specific endothelial cell receptor that forms a 1:1 stoichiometric complex with thrombin. This complex is responsible for the conversion of protein C to the activated protein C (protein Ca). Once evolved, protein Ca scissions the activated cofactors of the coagulation mechanism, factor Va and factor VIIIa, and thereby reduces the amount of thrombin generated.
-
基因功能參考文獻:
- Thrombomodulin gene C1418T polymorphism is associated with Kawasaki disease. PMID: 30008974
- SETD1A contributes to retinoic acid -induced thrombomodulin expression in vascular endothelial cells by modulating the activity and expression of KLF4. PMID: 29940355
- we for the first time demonstrated that TM binds to GPR15 via its EGF-like domain and exerts angiogenesis and cytoprotective function in vascular ECs. PMID: 28386128
- Bioinformatics analysis and screening of controls strongly suggested that the THBD-p.Trp153Gly mutation might be related to RPL aetiology. PMID: 29195508
- Taken together, our findings suggest that TM-PKCdelta interaction may contribute to cardiovascular disorders by affecting monocye differentiation, which may develop future therapeutic applications. PMID: 27910925
- A heterozygous variant displaying autosomal dominant inheritance (c.1611 C>A) was found in the gene THBD which encodes the glycoprotein thrombomodulin. This sequence change results in a stop codon (p.Cys537Stop) and truncation of the protein PMID: 28267383
- Lys 42, Lys 43, Lys 44 and Arg 12 are critical for the interaction of TAFI with the thrombin-thrombomodulin complex, which modulates its antifibrinolytic potential. PMID: 28640323
- Ligation of anti-HLA class I and II antibodies produces different effects on the endothelial expression of TBM and on serum levels of TBM in transplant recipients. PMID: 28239987
- Fibrinogen gamma acts as thrombomodulin II. (Review) PMID: 27784620
- Thrombomodulin (TM) promotes angiogenesis by enhancing cell adhesion, migration, and FAK activation through interaction with fibronectin. PMID: 27602495
- The elevation of serum thrombomodulin (sTM)level suggests that endothelial damage occurs in Abdominal Aortic Aneurysm pathogenesis. PMID: 28473982
- This population-based cohort study within the ARIC study did not replicate the Hernandez et al. finding that carrying the minor allele of 3 THBD SNPs doubles the risk of venous thromboembolism in African Americans. In fact, the HRs of VTE among carriers of the minor allele were <1. HRs were similar for white subjects. A strand-flip did not explain the discrepancies. PMID: 28619983
- these results suggest a novel function for thrombomodulin as an adhesion molecule in monocytes, where it enhances cell adhesion by binding Ley, leading to beta2 integrin activation via p38 MAPK PMID: 27808085
- TM, especially TME45, maintains vascular integrity, at least in part, via Src signaling. PMID: 27643869
- The present study found that the fifth epidermal growth factor-like domain of thrombomodulin (TME5) possesses the cytoprotective function in association with an increase in levels of anti-apoptotic myeloid cell leukemia-1 protein in an activated protein C-independent PMID: 27427915
- Case Report: CD141+ myeloid dentritic cell differentiation of a juvenile myelomonocytic leukemia. PMID: 28414089
- the effect of thromobomodulin c.1418C > T polymorphism on the pathogenesis of venous thrombosis PMID: 28710034
- The finding of a previously unrecognized fibrinolytic phenotype indicates that bleeding in Thrombomodulin-associated coagulopathy has a complex pathogenesis and highlights the pivotal role of TM as a regulator of hemostasis. PMID: 27436851
- TM mediates cell proliferation and migration via the Epithelial-To-Mesenchymal Transition (EMT) biomarkercyclooxygenase (COX)-2 PMID: 27512995
- the whole THBD gene sequenced in patients with recurrent venous thromboembolism (VTE); found 8 polymorphisms in the THBD gene in Swedish population; none of these polymorphisms was significantly associated with the risk of VTE recurrence; results indicate that THBD polymorphisms may not be a risk factor for VTE recurrence PMID: 28049360
- CORM-2 protects human umbilical vein endothelial cells from lipopolysaccharide-induced injury, by way of suppressing NF-kappaB activity, which downregulates TM and EPCR mRNAs. It also decreases MMP-2 expression and prevents the shedding of TM and EPCR from the surface of endothelial cells, so as to preserve their protective effect. PMID: 28538400
- The results demonstrate that the LFA-1 and Mac-1 integrins on leukocytes bind to thrombomodulin (TM), thereby establishing the molecular and structural basis underlying LFA-1 and Mac-1 integrin interaction with TM on endothelial cells. PMID: 27055590
- Human thrombomodulin transgenic aortic endothelial cells are less sensitive to activation by either HMGB1 or hTNFalpha, an effect that appears to be dependent on the lectin-like domain of TBM. PMID: 27077599
- In placenta of patients with preeclampsia, we detected abnormal expression of F3 and THBD with increased protein and mRNA levels. The role of these molecules in the pathogenesis of this disease and in alterations of hemostatic and histopathological aspects of placentas need further studying. PMID: 27002259
- recombinant TM (Solulin) can protect the intestine from toxicity in a clinically relevant rat model PMID: 27459702
- TM up-regulated E-cadherin but down-regulated N-cadherin expression, resulting in reversal of epithelial-mesenchymal transition (EMT) in the lung cancer cells. PMID: 27223053
- High serum thrombomodulin expression is associated with non-alcoholic fatty liver disease. PMID: 26959535
- results do not suggest a predictive role for THBD c.1418C>T polymorphism in VTE recurrence PMID: 26743062
- R12 is a critical residue for the activation of TAFI by thrombin-thrombomodulin PMID: 26816270
- Study detected a statistically significant positive correlation between expanded disability status scale scores and thrombomodulin levels (p<0.01) and a 10% positive correlation between expanded disability status scale scores and APC levels in multiple sclerosis patients PMID: 27456888
- Case Report: thrombotic microangiopathy with mutations in complement factor I and thrombomodulin. PMID: 26613809
- increased plasma TM levels and serum hs-CRP levels in cerebral infarction (CI) patients were associated with the development of CI in Asians. PMID: 26133301
- evidence of association between the -33G/A polymorphism in the TM gene and the risk of myocardial infarction in Asians; the Ala455Val variant was not associated with atherosclerotic risk [meta-analysis] PMID: 26888356
- Decreased thrombomodulin expression in preeclampsia may play a role in placental dysfunction in preeclampsia and is possibly caused by an angiogenic imbalance. Hypertension and obesity are associated with thrombomodulin downregulation. PMID: 26891741
- The presence of THBD proximal promoter polymorphisms do not explain variations in levels of serum and cell-expressed THBD in premature acute coronary syndrome patients in Bahrain. PMID: 26226255
- the functional relevance of the rs3176123 variation and indicate that higher thrombomodulin expression by individuals with the 2729C allele likely accounts for their decreased risk for acute GVHD development and subsequent mortality. PMID: 26246110
- The lack of any association between the sTM levels and genetic variants in ARDS suggests that the increased levels of sTM may reflect severity of endothelial damage rather than genetic heterogeneity. PMID: 25643902
- Identified Nur77/Nor1 as novel regulators of thrombomodulin expression and function in vascular endothelial cells. PMID: 26634653
- The results of this study supported the association of the epistatic interactions of ALOX5AP, THBD, and KNG1 and present novel evidence for the main effect of KNG1 gene on IS susceptibility. PMID: 26159646
- The EGF5, 6 domains of thrombomodulin appear to be the major domains for down-regulating the complement system rather than the lectin-like domain during xenogenic stimuli. PMID: 26179123
- A minimal TM fragment consisting of the fourth, fifth, and most of the sixth EGF-like domain (TM456m) that has been prepared has much improved solubility, thrombin binding capacity, and anticoagulant activity versus those of previous TM456 constructs. PMID: 26468766
- Data indicate that blood dendritic cell antigen 3 BDCA3(+) and C-type lectin domain family 9, member A CLEC9A(+) dendritic cells (DC) are of major importance in the induction of anti-viral and anti-tumor immunity. PMID: 24910448
- Recombinant thrombomodulin does not impair neutrophil functions. PMID: 25214376
- levels of protein C and soluble thrombomodulin in critically ill patients with acute kidney injury PMID: 25790110
- Membrane-bound TM in macrophages plays an essential role in the development of abdominal aortic aneurysms by enhancing proinflammatory mediator elaboration, macrophage recruitment, and oxidative stress. PMID: 26338301
- Cyclic strain strongly downregulated TM expression in a p38- and receptor tyrosine kinase-dependent manner in aortic endothelial cells. PMID: 25238231
- kinetics of the interaction between serine/threonine-rich domain of thrombomodulin (rTMD23) and FGFR1 were analysed in umbilical vein endothelial cells PMID: 25388665
- Thrombomodulin is differentially regulated within cultured brain microvascular endothelial cells by cytokines and shear stress. PMID: 25250518
- Review/Meta-analysis: TM -33G/A and Ala455Val polymorphisms were risk factors for coronary artery disease. PMID: 25144670
- function and regulation of BDCA3 expression and IFN-lambda production by dendritic cells PMID: 25616220
顯示更多
收起更多
-
相關疾病:Thrombophilia due to thrombomodulin defect (THPH12); Hemolytic uremic syndrome atypical 6 (AHUS6)
-
亞細胞定位:Membrane; Single-pass type I membrane protein.
-
組織特異性:Endothelial cells are unique in synthesizing thrombomodulin.
-
數據庫鏈接:
Most popular with customers
-
-
YWHAB Recombinant Monoclonal Antibody
Applications: ELISA, WB, IHC, IF, FC
Species Reactivity: Human, Mouse, Rat
-
-
-
-
-
-